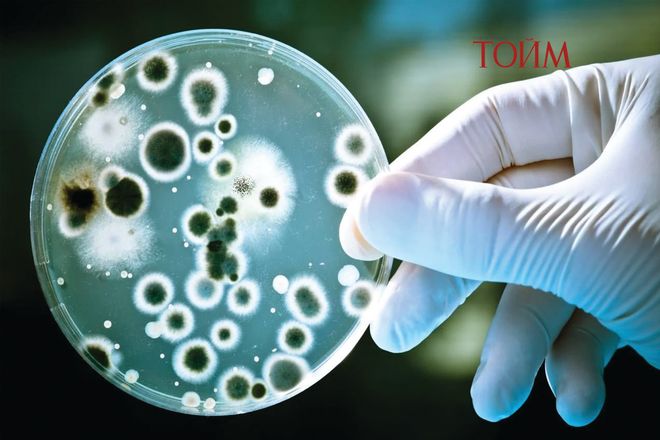

Румын улсын Скарисоара агуйн гүнд дэлхийн хамгийн том газар доорх мөсөн голуудын нэг оршино.
Олимпын стандарт хэмжээтэй 40 усан сантай тэнцэхүйц энэ аварга мөсөн биет ойролцоогоор 13000 жилийн өмнөөс үүсэж эхэлжээ. Энэ л агуйн мөсөнд булшлагдсан эртний бичил биетүүдийн судалгаа орчин үеийн түүхийг бид бичдэггүй гэдгийг харуулсан онцгой явдлын гэрч болж байна.
Агуйг судалж буй эрдэмтдийн мэдээлснээр тус агуйн мөснөөс хэлтлэн авч гэсгээн шинжлэхэд нэгэн нянгийн омог нь шээсний замын халдвар, сүрьеэ зэрэг өвчнийг эмчлэхэд хэрэглэдэг орчин үеийн 10 төрлийн антибиотикт тэсвэртэй байжээ. Энэ нян хүн төрөлхтөнд хортой гэсэн нотолгоо байхгүй, бас эсрэг нотолгоо ч байхгүй. Мянга мянган жилийн турш “унтаж” байсан бичил биетийг сэрээх нь шинжлэх ухааны уран зөгнөлт зохиол, киноны үйл явдал мэт сонсогдоно.
Судалгааны ахлах, Румыны ШУА-ийн Бухарестын Биологийн хүрээлэнгийн микробиологийн тэнхимийн ахлах судлаач Кристина Пуркаря
Эртний нянгууд орчин үеийн антибиотикт тэсвэртэй байдаг нь антибиотикт тэсвэржилт бол бичил биетүүдийн хоорондын өрсөлдөөний нөлөөгөөр хэдэн сая жилийн турш бүрэлдсэн хувьслын эртний шинж чанар юм.
“Frontiers in Microbiology” сэтгүүлд нийтлэгдсэн судалгааны дүнгээс харвал сая сая жилийн турш нянгууд хоорондоо холилдон амьдрахдаа жижиг хэмжээний ДНХ солилцох замаар ашигтай шинжүүдээ ч мөн дамжуулж чаддаг байжээ. Энэ нь төрөл зүйлийн хувьд хамааралгүй нянгуудын хооронд ч явагддаг хувьслын “зэвсгийн уралдаан” байсан аж. Амьд үлдэх энэхүү стратеги нь санамсаргүй байдлаар зарим нянгийн омгийг тодорхой антибиотикт үл ажрах “дархлаа”-тай болгосон байна. Судалгаанд тэмдэглэснээр ийм үзэгдэл эрс тэс орчинд амьдардаг бичил биетүүдийн дунд илүү түгээмэл байж.
“Орчин үеийн антибиотик нь тэсвэржилтийн тархалтыг хурдасгаж магадгүй. Гэхдээ энэ нь хүмүүс ийм эмийг бүтээхээс өмнө байгальд аль хэдийнэ оршин байсан молекулын механизмууд дээр тулгуурладаг” гэдгийг тус судалгааны ахлагч Кристина Пуркаря онцолжээ. Эрдэмтдийн үзэж байгаагаар энэхүү судалгаанаас олж авсан мэдлэг нь түгээмэл хэрэглэгддэг антибиотикоор эмчлэгдэхээ больсон орчин үеийн “супер нян”-тай тэмцэхэд тус дөхөм болох үүдийг нээж өгөх магадлалтай.

Агуйгаас олж судалсан шинэ омгийг Psychrobacter SC65A.3 гэж нэрлэдэг бөгөөд энэ нь хүйтэн орчинд үрждэг агаад хамгийн сайхан мэдээ нь хүнийг халдварлуулах чадваргүй гэнэ. Психрофил буюу хүйтэнд дурлагч бичил биетийн омог нь үнэндээ хүн төрөлхтөнд тун ойр хийгээд танил омог. Психобактер төрлийн ихэнх зүйлс мөс болон хөргөгчтэй орчинд, тэр дундаа хүнсэнд ч илэрдэг байна. Тодруулбал, хөлдөөсөн мах, загас, сүү болон бэлэн бүтээгдэхүүнд агуулагддаг байна.
Скарисоара агуйгаас авч судалгаанд ашигласан дээжийг “Их танхим” хэмээх хэсгээс 25 метр урт цилиндр хэлбэрийн мөсний цөмийг өрөмдөн авчээ. Уг цөмд 13000 жилийн турш хуримтлагдсан хөлдүү материал агуулагдсан бөгөөд судалгаанд ашигласан дээж нь 5000 жилийн настай мөснийх байв.
Лабораторид судлаачид янз бүрийн нянгийн омгийг тусгаарлаж, тэдгээрийн геномыг дараалал тогтоох аргаар шинжилж, аль генүүд нь бага температурт амьдрах боломж олгодог, аль нь антибиотикт тэсвэржилттэй холбоотойг тогтоожээ.
SC65A.3 омгийг бактерийн халдварыг эмчлэхэд түгээмэл хэрэглэдэг 28 төрлийн антибиотикт өртүүлэхэд 10-д нь тэсвэртэй байсан нь тогтоогдсон байна. Үүнд триметоприм, клиндамицин, метронидазол, рифампицин, ванкомицин зэрэг эмүүд багтжээ. Рифампицин сүрьеэг эмчлэхэд, ванкомициныг хүнд халдваруудын үед, ципрофлоксациныг олон төрлийн халдварт хэрэглэдэг.
Уг нян усны замын халдвар, арьсны, амьсгалын замын халдвар гэх мэт эмчилгээнд ашиглагддаг эмийн эсрэг тэсвэртэй гэсэн үг. Хэрвээ мөсөн агуй хайлвал хүн төрөлхтөн халдварт өвчиндөө давхар “живэх” магадлал тэр хэрээр өсөх бололтой.
Дэлхийн дулааралтай холбоотойгоор эртний бичил биетийн эрсдэлийг судалж буй цорын ганц баг тэд биш юм. Бусад судлаачид мөнх цэвдэгт хөлдүү байсан 48000 жилийн настай вирусийг сэргээж, удаан хугацаанд идэвхгүй байсан эмгэг төрөгчөөс өвчин дэгдэх магадлалыг судлах ажил үргэлжилж буй.
Энэхүү нээлт нь болзошгүй эрсдэл болон боломжийг хоёуланг нь агуулж байна. Судалгаагаар илэрсэн Psychrobacter SC65A.3 омог нь “супер нян”-тай тэмцэх хүн төрөлхтний тэмцэлд найдвар төрүүлж байгаа гол зүйл гэсэн сайн мэдээ бас бий. Геномын шинжилгээгээр бусад нян, мөөгөнцөр, вирусийг устгах эсвэл өсөлтийг нь зогсоох чадвартай байж болзошгүй 11 ген мөн илэрчээ.
SC65A.3 нь триметоприм, клиндамицин, метронидазол зэрэг зарим антибиотикт тэсвэртэй болох нь тогтоогдсон анхны Psychrobacter омог юм. Уг омгийн тэсвэржилтийн шинж нь хүйтэн орчинд дасан зохицсон нянгууд антибиотикт өртөх үед амьд үлдэх боломж олгодог ДНХ-ийн хэсгүүд болох тэсвэржилтийн генүүдийн “нөөц сан” болж чадна гэдгийг харуулж байна.
Дэлхийн дулаарал эрчимжиж, мөсөн голууд болон мөсөн агуйнууд хайлахын хэрээр мянга мянган жил хоригдсон бичил биетүүд гадагшилж болзошгүй гэх мэдээлэл энэ судалгааны хамгийн “аймаар” хэсэг нь биз. “Ихэнх нь хоргүй ч зарим нь антибиотикт тэсвэржилтийн ген, эсвэл одоогоор бидэнд үл мэдэгдэх биомолекул агуулж байж болзошгүй. Энэ нь өнөөгийн экосистемд нөлөөлж магадгүй” гэх ахлах судлаач Кристина Пуркарягийн үгийг хайхралгүй орхиж үл болно.
Хэрэв мөс хайлж эдгээр бичил биетүүдийг гадагшлуулбал, тэдний генүүд орчин үеийн нянгууд руу тархаж, дэлхий дахинд тулгамдаж буй антибиотикт тэсвэржилтийн асуудлыг улам хүндрүүлж болзошгүй.
Нөгөө талаас тэд өвөрмөц фермент болон нянгийн эсрэг нэгдлүүдийг үүсгэдэг бөгөөд энэ нь шинэ антибиотик, үйлдвэрийн фермент, бусад биотехнологийн шинэчлэлд урам зориг өгөх боломжтой аж. Psychrobacter SC65A.3-ын генетикийн шинжилгээгээр үүрэг нь тодорхойгүй бараг 600 ген илэрсэн нь шинэ биологийн процессуудыг нээх бүрэн ашиглагдаагүй нөөц байж болохыг харуулжээ. Мөн судалгааны баг нян, мөөгөнцөр, бүр вирусийг устгах эсвэл өсөлтийг нь саатуулах чадвартай байж болзошгүй 11 генийг ч илрүүлжээ.
Дэлхий даяар антибиотикт тэсвэржилт нэмэгдсээр байгаа энэ үед эртний бичил биетээс олж авсан цоо шинэ энэ мэдлэг улам бүр үнэ цэнтэй болж байна. Мөсөнд хадгалагдсан геномуудыг судлах нь орчин үеийн анагаах ухаан бий болохоос өмнө тэсвэржилт хэрхэн үүсч, хэрхэн тархсаныг судлах боломж олгожээ. Гэхдээ лабораторид маш болгоомжтой харьцаж, аюулгүй ажиллагааны арга хэмжээг чанд мөрдөх нь хяналтгүй тархалтын эрсдэлийг бууруулахад зайлшгүй шаардлагатай гэдгийг судалгааны багийнхан онцлон дурдсан байна. Ихэнх антибиотикийг хөрсөнд амьдардаг бичил биетээс илрүүлж, нян ба мөөгөнцрөөс гарган авдаг. Гэвч сүүлийн хэдэн арван жилд эмийг хэтрүүлэн хэрэглэснээс болж олон эмгэг төрөгч эдгээр эмэнд тэсвэртэй болжээ. ДЭМБ-ын мэдээлснээр “антибиотикт тэсвэржилттэй” гэх оноштой холбоотойгоор дэлхий даяар жил бүр ойролцоогоор таван сая хүн нас бардаг аж.
Нянгийн эсрэг эмийн тэсвэржилт (Antimicrobial Resistance, AMR) нь дэлхий даяар жил бүр сая сая хүний аминд хүрч байна. Европт жил бүр 35000 гаруй нас баралтын шалтгаан болж байгаа “тэсвэржилт”-ийн тоо өсөх төлөвтэй гарчээ. Өнгөрсөн жил Европын Өвчнөөс урьдчилан сэргийлэх, хяналтын төвөөс мэдээлснээр тус бүс нутагт нянгийн эсрэг эмийн тэсвэржил тархах таатай нөхцөл бүрдэхэд хэд хэдэн хүчин зүйл нөлөөлжээ.
Үүнд:
- Европын хүн ам хөгширч, халдварт өвчинд илүү
өртөмтгий болсон;
- Эмэнд тэсвэртэй эмгэг төрөгчид улс орнуудын хил дамнан тархаж
байгаа;
- Эмч болон өвчтөнүүд антибиотикийг хэтрүүлэн, зохисгүй хэрэглээ
ихэссэн;
- Халдвараас сэргийлэх, хяналт тавих тогтолцоо төгс бус хэвээр байгаа
зэрэг нь нөлөөлсөн байна.
ДЭМБ-ын мэдээлснээр одоогоор дэлхий даяар бүртгэгдэж буй бактерийн халдварын зургаан тохиолдлын нэг нь стандарт эмчилгээнд тэсвэртэй болсон байна. Их Британийн Оксфордын их сургуулийн эмийн химийн чиглэлийн докторын дараах судлаач Мэттью Холландын хэлснээр судлаачид мөсөн агуй, далайн ёроол зэрэг шинэ, эрс тэс орчноос шинэ антибиотик болгох боломжтой биомолекулуудыг хайсаар байгаа аж. “Румын дахь багийн илрүүлсэн энэ нян 10 синтетик антибиотикт тэсвэртэй байсан нь сонирхолтой. Гэхдээ үүнээс гадна аль хэдийнэ тэсвэртэй, хор хөнөөлтэй нянгуудыг устгах чадвартай молекул ялгаруулдаг болохыг тэд тогтоосон. Тиймээс түүний үүсгэдэг молекулуудыг судлаад шинэ антибиотик бүтээх боломж байгаа эсэхийг харах нь найдвар төрүүлж байна. Энэ төрлийн зарим зүйл нь хүн болон амьтанд халдвар үүсгэх боломжтой боловч биотехнологийн салбарт ашиглах ирээдүйтэй гэж мөн үздэг” гэж судлаач Мэттью Холланд хэлжээ.
Нэг багийн судлаачдын нээсэн аюул, эрсдэлийг нөгөө хэсгийн судлаачид боломж болгож чадах эсэхээс бидний ирээдүй хэр урт байх нь шийдэгдэх бололтой. Эрсдэл ба боломж үргэлж зоосны талууд байсаар ирсэн билээ.